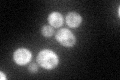
YBR155W
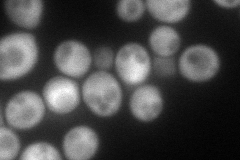
YBR155W
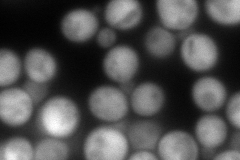
YBR155W
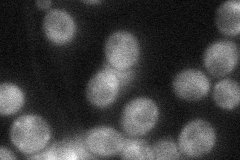
YBR155W
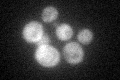
YBR155W

View description
TPR-containing co-chaperone; binds both Hsp82p (Hsp90) and Ssa1p (Hsp70) and stimulates the ATPase activity of SSA1, ts mutants reduce Hsp82p function while over expression suppresses the phenotypes of an HSP82 ts allele and a cpr7 deletion
Localization:
Intensity:
Fold change:
Significance:
-
C’ GFP library in SD
cytosol56.38 -
N' NOP1pr-GFP in SD
cytosol138.495 -
N' TEF2pr-mCherry in SD
cytosol249.982 -
N' NATIVEpr-GFP in SD
cytosol38.2629 -
N' TEF2pr-VC and Cyto-VN in SD

#N/A0 -
C’ GFP library in SD+DTT

cytosol39.910.7No -
C’ GFP library in SD+H2O2
cytosol51.380.91No -
C’ GFP library in Starvation Media

cytosol58.891.04No -
C’ GFP library on the background of Pup2-DaMP

cytosol -
C’ GFP library on the background of CCT mutant

cytosol56.47921.00168No
